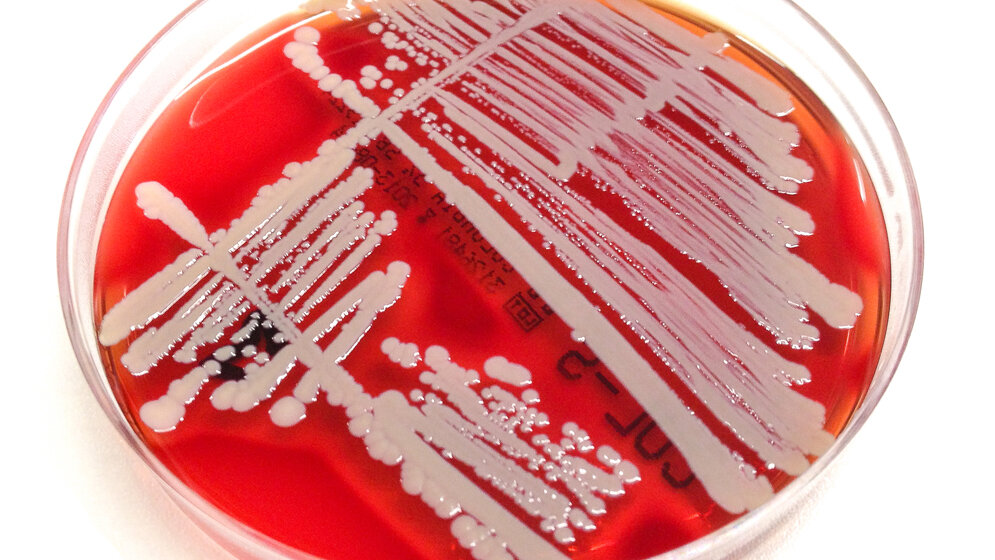
Bakterienkultur von Staphylococcus aureus

In den letzten Jahren werden Kinderärzte und Eltern vermehrt mit der Problematik multiresistenter Keime konfrontiert. Laut einer Zufallsdiagnose ist ein Kind Träger eines gegen zahlreiche Antibiotika resistenten Erregers. Häufig ist jedoch unklar, wie ein solcher Befund zu interpretieren ist und welche Schritte zu ergreifen sind.
Eine gute Beratung kann inadäquate Maßnahmen verhindern, die unter Umständen die Lebensqualität von Kind und Familie erheblich einschränken. Gerade bei Eltern besteht hoher Informationsbedarf, um Ängste und Verunsicherung zu vermeiden. Daher hat die Arbeitsgruppe Pädiatrische Infektiologie am Universitätsklinikum Bonn mit der Internetplattform „MRSA-Kinder.net“ ein neues Informations- und Beratungsangebot für Eltern, Ärzte, Gesundheitsämter und Betreuungseinrichtungen etabliert.
Immer öfter in Kontakt mit MRSA
Vor allem auf der Schleimhaut der oberen Atemwege, aber auch auf der Haut können Bakterien mit dem Namen „Staphylococcus aureus“ leben. In der Regel sind diese Bakterien unproblematisch, aber bei kranken und geschwächten Menschen können sie zu Infektionen führen. Antibiotika helfen in solchen Fällen, doch manche dieser Bakterien sind gegenüber Antibiotika unempfindlich, die so genannten „Methicillin-resistenten Staphylococcus aureus“ – kurz MRSA. Immer häufiger kommen auch gesunde Kinder mit MRSA und anderen multiresistenten Keimen außerhalb der Krankenhäuser in Kontakt.
Die Arbeitsgruppe Pädiatrische Infektiologie am Zentrum für Kinderheilkunde des Universitätsklinikums Bonn betreut seit Jahren intensiv Familien mit betroffenen Kindern. Aufgrund des zunehmenden Beratungsbedarfs gründete sie 2012 die erste MRSA-Ambulanz für Kinder in Nordrhein-Westfalen. „Unser Ziel ist es, betroffenen Kindern, ihren Familien und den betreuenden Kinderärzten kompetent und zeitnah zu helfen“, sagt der Leiter der Arbeitsgruppe Pädiatrische Infektiologie Prof. Dr. Andreas Müller.
Beratungsbedarf zum Thema MRSA im Kindesalter nimmt stetig zu
Neben einer zunehmenden Zahl an ambulanten Betreuungen von Kindern mit MRSA-Infektionen/Besiedlung, werden auch stetig mehr Beratungsanfragen von niedergelassenen Kinderärzten, Klinikärzten und Gesundheitsämtern aus dem gesamten Bundesgebiet verzeichnet. Über 200 schriftliche und telefonische Anfragen bezüglich MRSA im Kindesalter pro Jahr beantwortet die Bonner Arbeitsgruppe Pädiatrische Infektiologie. Etwa drei von vier Anfragen bei der Bonner MRSA-Ambulanz für Kinder drehen sich um allgemeine Informationen zu MRSA, Dekolonisationsbehandlungen, allgemeines Vorgehen bei Nachweis von MRSA-Besiedlung sowie MRSA in Gemeinschaftseinrichtungen.
Bedarfsangepasste Informationen
„Um weiterhin niederschwellig Informationen sowie Beratungen bei speziellen Fragen anbieten zu können, haben wir das ‚Kinder-MRSA-Netzwerk’ gegründet“, sagt Dr. Till Dresbach, der als Oberarzt für Kinder- und Jugendmedizin die Ambulanz koordiniert. Die Internetplattform „www.mrsa-kinder.net“ stellt Inhalte zum Thema „MRSA bei Kindern“ bereit – und zwar bedarfsangepasst für die unterschiedlichen Zielgruppen wie niedergelassene und klinisch tätige Kinderärzte, Eltern, Gesundheitsämter und Betreuungseinrichtungen.
Die Koordination des Netzwerkes MRSA-Kinder.net erfolgt federführend durch die Pädiatrische Infektiologie am Universitätsklinikum Bonn. Ein wissenschaftlicher Beirat, bestehend aus Pädiatrischen Infektiologen, Fachärzten für Mikrobiologie sowie Krankenhaushygienikern, ermöglicht eine umfangreiche und zeitnahe Beantwortung auch von komplexen Fragestellungen. Das Projekt wird unterstützt von der Deutschen Gesellschaft für Pädiatrische Infektiologie (DGPI), der Expertengruppe Paed IC sowie dem Förderverein für Kinder mit seltenen Infektionskrankheiten, Bonn e.V. (Uniklinik Bonn, red)
Hier geht es zur Internetplattform.
Artikel teilen